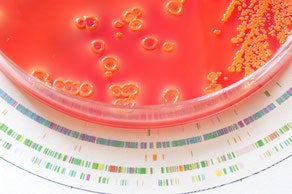

The gut microbiome forms a reservoir for opportunistic pathogens as well as for antimicrobial resistance genes. This finding is important because it offers a deeper insight in the dynamics and mechanism of antimicrobial resistance development. This project – supported by a grant from the Netherlands Centre for One Health – was performed by Paul Stege who defended his PhD thesis on November 9, 2022 at Utrecht University.
The intestinal tract is densely colonized by hundreds of different bacteria, viruses and fungi that together make up the gut microbiome. This microbiome can contribute to host immunity, and therefore plays a role in the protection against pathogens. Furthermore, specific bacteria are associated with intestinal disorders and disease. PhD candidate Paul Stege (Department of Medical Microbiology, UMC Utrecht) and colleagues from the Microbial Genomics & Microbiomics research group (prof. dr. Rob Willems) therefore investigated the role of the gut microbiome in the defence against opportunistic bacteria and in the transfer of antibiotic resistance genes (ARGs), the latter which is involved in the development of antimicrobial resistance.
In one of the studies, Paul Stege focused on the environmental driven changes in the microbiome In humans and dogs and how this can affect the abundance of ARGs. Next, he studied the interplay between human gut tissue and a specific opportunistic pathogen, Enterococcus faecium. By analysing the microbiome composition of healthy Dutch residents with different diets, he observed that vegans had a microbiome composition that differed somewhat from omnivores, pescatarians and vegetarians (possibly because vegans do not consume dairy products). Diet, however, did not seem to influence the composition of ARGs in the gut.
Stege and colleagues also analysed how the gut colonization of extended spectrum β-lactamase producing Escherichia coli (ESBL-EC) in dogs affects the composition of the microbiome and ARGs. They observed that dogs colonized by ESBL-EC had a higher abundance of some possible pathogens and specific ARGs.They also described, using an organoid model, how specific genes play a crucial role in the gut colonization of E. faecium. Finally, Paul Stege developed a tool based on the CRISPR-Cas9 system that can make make knockouts on specific genes in the E. faecium genome. With the help of this tool, investigators may be able to determine the exact role of these genes during gut colonization in future studies.
Paul Stege concludes: “The innovative techniques and tools that we used have helped us to demonstrate that the gut microbiome forms a reservoir for opportunistic pathogens as well as for ARGs. Furthermore, our research shows how the organoid technology can be used to investigate interactions between opportunistic pathogens and intestinal cells”.
This research project was financially supported by the Netherlands Centre for One Health (NCOH) as part of its strategic research program for PhD candidates under the topic ‘Complex Systems & Metagenomics’. In this research topic, the complex interactions are investigated between environments, between animals and humans, microbes or genes and their products that affect infectious disease dynamics and the epidemiology of pathogens. The projects in this program tackle various aspects of these interactions, such as transmission of microbial strains or mobile genetic elements such as ARGs, susceptibility to infection and selection for resistant microorganisms. The PhD candidates investigate the use of metagenomic analysis of the microbiome at the animal-human-environmental interface. They also aim to develop novel methods to describe the complex dynamics of dissemination of (antibiotic resistance) genes and pathogens and examine effects on the development of (infectious) diseases or syndromes, host processes, and the environment.
Paul Stege (1993, Groningen) defended his PhD thesis on November 9, 2022 at Utrecht University. The title of his thesis is “Making yourself at home in the intestinal tract – Dynamics of the microbiome, resistome and host-pathogen interactions.” Supervisor was prof. dr. Rob Willems (Department of Medical Microbiology, UMC Utrecht). Co-supervisor was dr. Fernanda Paganelli (Department of Medical Microbiology, UMC Utrecht; now at Janssen Pharmaceutical Companies, Raritan NJ, USA). As of early 2022, Paul Stege works as a bioinformatician at Wageningen Bioveterinary Research (part of Wageningen University & Research) in Lelystad.